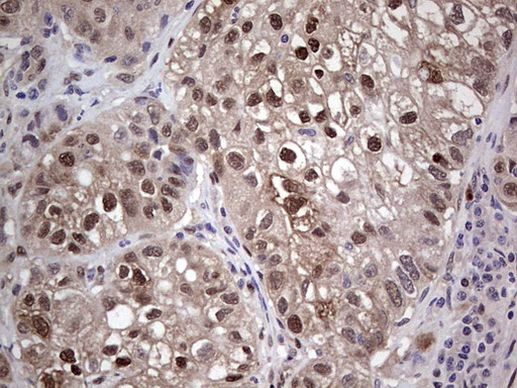
PTGS2 Antibody in Immunohistochemistry (Paraffin) (IHC (P))

Search
OriGene
PTGS2 Monoclonal Antibody (OTI10H5), TrueMAB™
{{$productOrderCtrl.translations['antibody.pdp.commerceCard.promotion.promotions']}}
{{$productOrderCtrl.translations['antibody.pdp.commerceCard.promotion.viewpromo']}}
{{$productOrderCtrl.translations['antibody.pdp.commerceCard.promotion.promocode']}}: {{promo.promoCode}} {{promo.promoTitle}} {{promo.promoDescription}}. {{$productOrderCtrl.translations['antibody.pdp.commerceCard.promotion.learnmore']}}
产品信息
TA805307
种属反应
宿主/亚型
分类
类型
克隆号
抗原
偶联物
形式
浓度
纯化类型
保存液
内含物
保存条件
运输条件
靶标信息
COX2 converts arachidonate to prostaglandin H2 (PGH2), a committed step in prostanoid synthesis, including production of inflammatory prostaglandins. The conversion of arachidonate to prostaglandin H2 is a 2 step reaction: a cyclooxygenase (COX) reaction which converts arachidonate to prostaglandin G2 (PGG2) and a peroxidase reaction in which PGG2 is reduced to prostaglandin H2 (PGH2). It is constitutively expressed in some tissues in physiological conditions, such as the endothelium, kidney and brain, and is up-regulated under pathological conditions, such as in cancer and inflammation (in contrast to the iso-enzyme PTGS1, which is expressed ubiquitously). Up-regulation of COX2 is also associated with increased cell adhesion, phenotypic changes, resistance to apoptosis and tumor angiogenesis. In cancer cells, COX2 is a key step in the production of prostaglandin E2 (PGE2), which plays important roles in modulating motility, proliferation and resistance to apoptosis. COX2 is naturally inhibited by calcitriol (the active form of Vitamin D). Glucocorticoids chronically trans-repress PTGS2 gene activity in vivo in part by interfering with transcription initiation and elongation. COX2 is a target of NSAID such as aspirin, which can reduce pain and swelling from inflammation driven by COX2.
仅用于科研。不用于诊断过程。未经明确授权不得转售。
篇参考文献 (0)
生物信息学
蛋白别名: COX-2; cyclooxygenase; cyclooxygenase 2; cyclooxygenase 2b; Cyclooxygenase-2; PGH synthase 2; PHS II; Prostaglandin G/H synthase 2; Prostaglandin H2 synthase 2; Prostaglandin-endoperoxide synthase 2; prostaglandin-endoperoxide synthase 2 (prostaglandin G/H synthase and cyclooxygenase)
基因别名: COX-2; COX2; GRIPGHS; hCox-2; PGG/HS; PGHS-2; PHS-2; PTGS2
UniProt ID: (Human) P35354
Entrez Gene ID: (Human) 5743